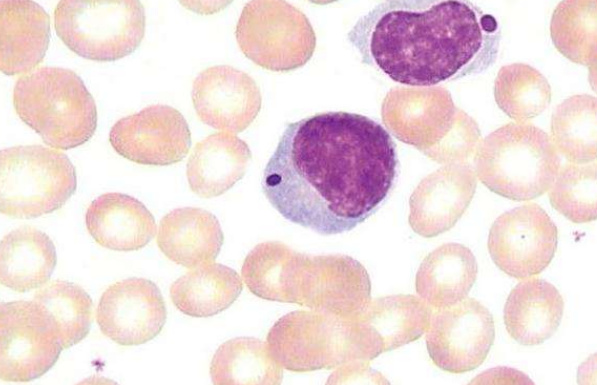

【资讯导读】慢性粒细胞性白血病始于慢性期,在此期间很少或没有临床问题发生。但是,如果不加以治疗,则慢性期会发展为急性期。这些阶段称为加速期和增生期,其特征是快速增长的侵略
慢性粒细胞性白血病始于慢性期,在此期间很少或没有临床问题发生。但是,如果不加以治疗,则慢性期会发展为急性期。这些阶段称为加速期和增生期,其特征是快速增长的侵略性癌症。达到这些急性期的患者长期生存预后较差。
费城染色体阳性(Ph阳性)CML是指大多数CML病例,其中遗传异常(称为费城染色体)导致癌细胞不断激活的生长。大约有30%的成人急性淋巴细胞白血病(ALL)患者也患有这种遗传异常。
格列卫(甲磺酸伊马替尼)是一种生物药剂,可结合并减缓或阻止具有费城染色体遗传突变的癌细胞的失控生长。尽管格列卫在大部分Ph阳性CML患者中产生持续的抗癌反应,但仍有一些患者停止对格列卫的反应或无法耐受格列卫。除非这些患者接受干细胞移植,否则治疗选择仍然有限。
尼洛替尼是一种药物,它也靶向与格列卫相同的蛋白质,但通过不同的机制。一些试验表明,尼洛替尼比格列卫更有效。促使FDA批准厄洛替尼的临床试验评估了接受过格列卫治疗的CML患者中的尼洛替尼。用尼洛替尼治疗的患者在耐受治疗良好的同时血细胞水平有所改善。
欧洲研究人员进行了一项研究,以进一步评估Tasigna对已停止对格列卫产生反应的CML患者的治疗。这项研究的结果表明,厄洛替尼是有效的:慢性期CML患者中78%的患者的血细胞水平得到改善,加速期CML患者中75%的患者和爆炸危险中25%的患者血细胞水平得到改善。
研究人员得出结论,这些结果提供了其他证据,表明厄洛替尼在已停止对格列卫应答的CML患者中产生了显着的抗癌活性。
尼洛替尼药品详细信息请进入:https://www.inmedf.com/zhongliu/fei/2019112.html